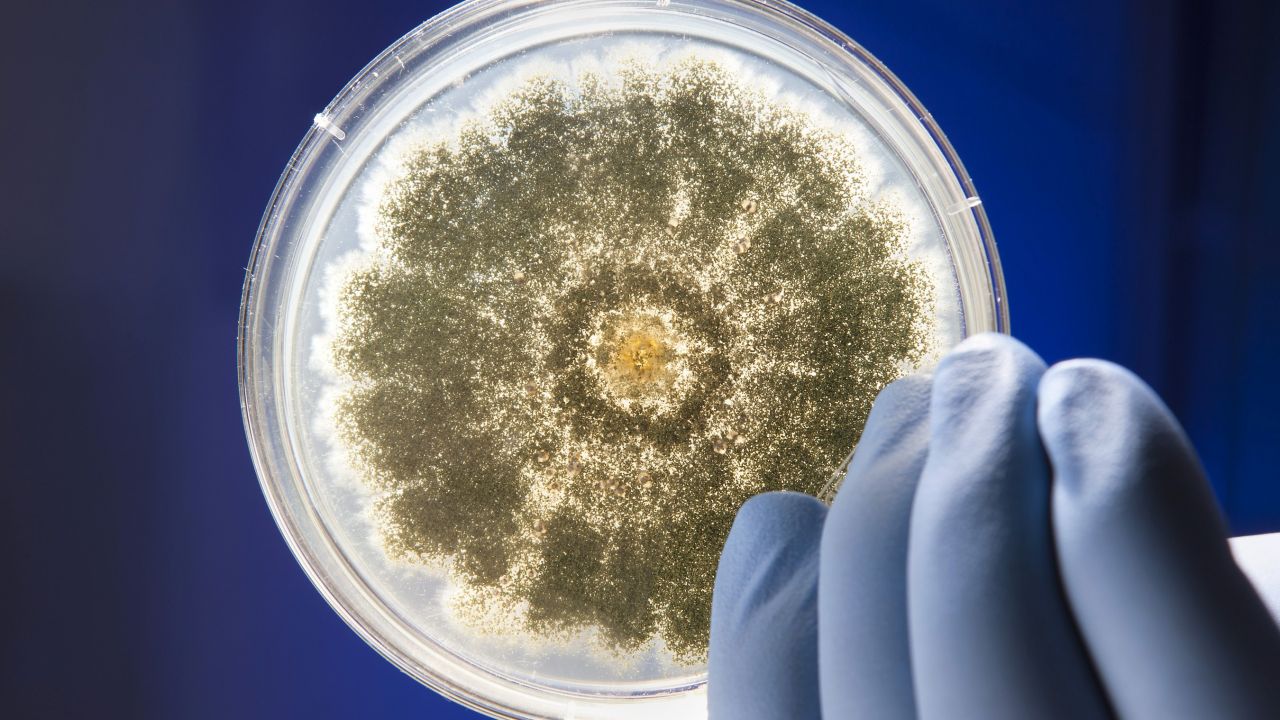

新一代口服標靶BTK抑制劑10月起納入給付 為血癌病友開啟希望新篇章
2025-09-25 / 新聞中心
九月為全球血癌宣導月,台灣健保再次展現制度前瞻性與國際接軌力,一次推動三大適應症給付,將新一代口服標靶BTK抑制劑擴及濾泡性淋巴瘤(FL)、慢性淋巴性白血病(CLL)、被套細胞淋巴瘤(MCL)。政策將於今年10月1日正式上路,不僅翻開台灣治療新篇章,更突破治療瓶頸、縮短國際落差,為血癌病友帶來真正的治療曙光。衛生福利部中央健康保險署陳亮妤署長今(25)日表示:「健保署持續致力於提升藥品可近性,給付...
驗證CAR‑T療法新突破!賓大攜手紐約大首創「白血病晶片」登《Nature》子刊
2025-07-10 / 實習記者 康芸榛
近(1)日,美國賓州大學佩雷爾曼醫學院(PerelmanSchoolofMedicineattheUniversityofPennsylvania)與紐約大學坦登工程學院(TandonSchoolofEngineeringatNewYorkUniversity)的研究團隊,共同研發出全球首個結合人類骨髓結構和免疫系統的微型裝置——白血病晶片,不僅可以模擬白血病患者體內的腫瘤...
《Nature》子刊:千年古墓黴菌新發現 有望成白血病新藥?
2025-07-01 / 實習記者 康芸榛
6月23日,美國賓州大學研究團隊最新研究,從古墓真菌黃麴黴(Aspergillusflavus)中發現一類全新化合物——Asperigimycins。該化合物由核糖體合成並經酵素修飾產生,屬於全新結構類型,不僅能高效對抗白血病細胞,效果與目前美國食品藥物管理局(FDA)核准的白血病藥物(如cytarabine、daunorubicin)相當,具有成為抗癌新藥的潛力。該研究發...
彭汪嘉康院士NCI 30年染色體、癌症成就 登美國國家衛生院期刊!
2024-11-19 / 記者 彭梓涵
11月8日,美國國家衛生研究院(NIH)為被譽為台灣「癌症研究之母」、中研院院士彭汪嘉康舉辦了展覽,並在NIH出版刊物中報導她的傑出成就。彭汪嘉康在美國國家癌症研究所(NCI)擔任細胞遺傳研究室主管超過30年,為癌症研究領域作出重大貢獻。儘管目前已逾90歲,她依然活躍於生醫領域,並積極推動公共教育與人才培育。 NCI30年職涯致力染色體、癌症研究 彭汪嘉康是台大醫學院第一位接受外科手術訓練的女...
《Nature》 CAR-T加上幹細胞特性 有望提升抗癌潛力?!
2024-04-11 / 實習記者 鐘御慈
昨(10)日,發表於《Nature》的兩篇研究發現,提高一種名為FOXO1的蛋白質濃度能改變CAR-T(ChimericAntigenReceptorTCells)細胞,還發現一種名為IL-15的免疫分子可以啟動與FOXO1相關的基因,增加FOXO1濃度,使CAR-T細胞活性類似於幹細胞,能更有效地對抗癌症。 CAR-T細胞是從接受癌症治療或其他疾病患者的血液中分離出的T細胞所製成,其經過基因修改...
一次囊括兩適應症!FDA批准BMS首款CLL、SLL白血病CAR-T療法
2024-03-18 / 記者 彭梓涵
近(15)日,必治妥施貴寶(BMS)宣布,其開發CAR-T療法Breyanzi再添適應症,獲得美國食品藥物管理局(FDA)加速批准,用於曾接受BTK抑制劑治療後,復發或難治的慢性淋巴性白血病(CLL)和小淋巴球性淋巴瘤(SLL),成為第一款可治療CLL或SLL的CAR-T療法。 Breyanzi是一種針對CD19的CAR-T細胞療法,在一項名為TRANSCENDCLL004的臨床1/2期開放標籤、...
輝瑞多發性骨髓瘤雙特異性抗體藥獲FDA批准;兒童受試者死亡 2seventy bio 白血病CAR-T療法暫停;智抗糖App推AI食物辨識功能
2023-08-15 / 編輯部
《臺灣》智抗糖App推AI食物辨識功能協助糖友快速記錄飲食 今(15)日,Health2Sync智抗糖宣布於其開發的最新版「智抗糖App」中,正式推出「AI食物辨識」功能,用戶只需透過手機拍照,即可一鍵辨識食物種類;只要再選擇食物份量,App即可自動帶入總熱量與碳水化合物、蛋白質、脂質等三大類營養素資訊。 Health2Sync表示,此功能不但可幫助慢性病患更輕鬆、快速記錄日常飲食,養成良好記錄習...
漢達白血病505(b)(2)新藥 獲FDA完全回覆信函 將補臨床資料
2023-05-02 / 記者 李林璦
近(4月28)日,漢達生技(6620)公告,其開發的白血病用藥HND-033,已於美國時間4月27日收到美國食品藥物管理局(FDA)完全回覆信函CRL(CompleteResponseLetter),要求進一步補充說明審查送件資料中臨床試驗相關之數據。漢達生技表示,將與美國FDA進行溝通,說明其臨床試驗之設計及相關結果依據,同時準備CRL中提及需補強之相關資料,於最快時間內對FDA所提出之意見進行...
04/21世界急性骨髓性白血病日(AML Day)
2021-04-21 / 環球生技
四月廿一日是世界急性骨髓性白血病(AML)日,急性骨髓性白血病(Acutemyeloidleukemia,AML)是一種骨髓性血液細胞過度增生造成的癌症。此疾病主要影響中老年族群,整體而言5年生存率僅有30%,但超過65歲的患者只有10%。更可怕的是,即使是在初次接受化療後達到完全緩解AML也經常復發。白血病(leukemia)一詞由德國病理學家魯道夫·菲爾紹(RudolfLudwi...
AZ白血病新藥 有望逆轉肺部纖維化
2020-08-07 / 記者 王棋祺
近(6)日,辛辛那提兒童醫院(CincinnatiChildren’sHospitalMedicalCenter)的研究團隊,根據一項臨床前研究(pre-clinicalstudy )中顯示,barasertib在小鼠中可以逆轉特發性肺部纖維化( idiopathicpulmonaryfibrosis ,IPF)患者的肺部纖維細胞的活化。這項研究已經發表在《EMBOMolecularM...